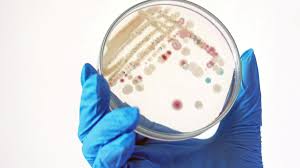
Casos de bactérias carnívoras estão crescendo nos EUA; entenda

Registros de infecção por Vibrio vulnificus aumentaram 800% na Costa Leste dos EUA; cientistas culpam mudanças climáticas pelo crescimento
Logo ao sudoeste de Nova Orleans, em uma tranquila vila de pescadores no pântano da Louisiana, Linard Lyons passou a manhã em seu barco de 19 pés, preparando armadilhas para caranguejos para seus netos, como já havia feito milhares de vezes antes. Desta vez, ele notou um pequeno arranhão em sua perna – um arranhão que quase lhe custou a vida.
Lyons seguiu seu dia normalmente, mas acordou na manhã seguinte se sentindo “delirante”. Com febre e vômitos, inicialmente pensou que tinha apenas contraído uma virose estomacal, mas então descobriu uma série de feridas enegrecidas se espalhando por sua perna esquerda.
Em uma decisão que acabou salvando sua vida, ele foi direto ao seu médico de família. Lyons conta à CNN que seu médico imediatamente soube “exatamente do que se tratava” e o encaminhou diretamente para a emergência. Em “questão de talvez uma hora”, Lyons se encontrava na sala de cirurgia do hospital.
Aquele pequeno arranhão na perna de Lyons tornou-se a porta de entrada para a Vibrio vulnificus, também conhecida como bactéria carnívora. As feridas negras em sua perna indicavam fasciíte necrosante, que “afeta o tecido sob a pele”, segundo a Cleveland Clinic.
Essas bactérias potencialmente letais são encontradas naturalmente e prosperam em águas costeiras durante os meses mais quentes, especialmente em águas salobras, onde a água doce encontra o mar, de acordo com os Centros de Controle e Prevenção de Doenças dos EUA (CDC). Antes largamente confinadas à Costa do Golfo, os casos aumentaram ao longo da Costa Leste, com um aumento de 800% entre 1988 e 2018, segundo o CDC.
50/50 de chance de sobrevivência
“Tenho sua permissão para fazer o que for necessário para salvar sua vida?” perguntou o médico de Lyons.
Estas foram as últimas palavras que Lyons se lembra de ter ouvido antes da cirurgia. Ele imediatamente entendeu a gravidade da situação e percebeu que sua perna poderia ter que ser amputada. “Me deram 50% de chance de sair vivo do hospital naquele momento”, afirma.
Seus cirurgiões conseguiram tanto remover a infecção quanto salvar a perna de Lyons. Após três dias na unidade de terapia intensiva, três semanas no hospital e diversos antibióticos, ele foi “liberado da bactéria”.
Já se passaram mais de três meses desde que ele contraiu a bactéria carnívora, mas sua recuperação está longe de terminar.
A recuperação não tem sido confortável para Lyons, que tem diabetes; ele a descreve como um “sofrimento”. No entanto, ele mantém a esperança de que um enxerto de pele será a etapa final para que sua perna volte ao “normal”.
A Vibrio vulnificus geralmente não deve representar um risco fatal para uma pessoa comum, diz à CNN Daniel Edney, Oficial de Saúde do Estado do Mississippi. Pessoas com sistema imunológico enfraquecido têm um risco maior de contrair uma infecção, afirma Edney.
Se você planeja estar em água costeira, assuma que ela está contaminada com Vibrio e evite a água se tiver “cortes ou feridas que possam ser potencialmente infectados”, segundo Edney.
No entanto, a infecção por Vibrio não ocorre apenas através do contato de feridas com a água. Também pode surgir do consumo de certos alimentos.
A pequena impressão no menu
“O consumo de carnes, aves, frutos do mar, mariscos ou ovos crus ou mal cozidos pode aumentar seu risco de doenças transmitidas por alimentos, especialmente se você tiver certas condições médicas.”
Este aviso, frequentemente encontrado em letras pequenas no rodapé dos cardápios de restaurantes, pode parecer familiar. Na Louisiana, este aviso específico deve estar “claramente visível” em todos os estabelecimentos que vendem ou servem ostras cruas – com poucas exceções – de acordo com o Departamento de Saúde da Louisiana.
A vibriose também pode ser contraída ao comer mariscos crus ou mal cozidos. Na maioria das vezes, é uma infecção menos grave causada por um tipo diferente da bactéria, causando apenas desconforto estomacal, mas ocasionalmente pode encontrar seu caminho na corrente sanguínea, segundo o CDC.
As ostras obtêm seu alimento filtrando a água do mar. Quando essa água está repleta de bactérias, uma única ostra pode conter até um milhão de células de Vibrio vulnificus, de acordo com Jim Oliver, professor da Universidade da Carolina do Norte em Charlotte.
O risco mais amplo
Embora seja raro, “muitas pessoas com infecção por Vibrio vulnificus podem ficar gravemente doentes e precisar de terapia intensiva ou amputação de membros. Cerca de 1 em cada 5 pessoas com esta infecção morre, às vezes em um ou dois dias após adoecer”, segundo o CDC.
A Louisiana foi um dos primeiros estados a chamar a atenção para esta infecção nesta temporada após ver um aumento nos casos.
Até o final de julho, as autoridades relataram 17 hospitalizações e quatro mortes entre residentes da Louisiana, mais do que o dobro do que normalmente veem. Pelo menos três novos casos foram relatados em agosto.
Este vírus potencialmente letal não é exclusivo dos estados do Golfo e está sendo encontrado cada vez mais ao norte conforme as temperaturas da água aumentam.
O Departamento de Saúde Pública de Massachusetts identificou um caso “extremamente raro” de Vibrio vulnificus em um residente exposto à água costeira próxima a Martha”s Vineyard. Até agora este ano, Massachusetts confirmou 71 casos, com taxa de hospitalização de 30% e nenhuma morte.
Massachusetts, no entanto, não é o único estado da Costa Leste relatando aumento de casos. Autoridades do Departamento de Saúde da Virgínia afirmam que os casos de vibriose entre seus residentes vêm “aumentando nos últimos dez anos”.
Os casos na Carolina do Norte aumentaram 620% nos últimos 10 anos, e os de Nova York mais que triplicaram.
As alterações climáticas alimentam a propagação
Os oceanos estão ficando mais quentes e o nível do mar está subindo devido às mudanças climáticas causadas pelo homem, e cientistas alertam que esses fatores estão aumentando o risco de infecções por Vibrio.
Oliver, professor da UNC Charlotte, acrescenta que o derretimento das geleiras está reduzindo a salinidade do oceano – outro fator que aumenta a ameaça. “A água salgada do mar aberto tem uma taxa de salinidade muito alta para o Vibrio vulnificus“, explicou ele. Mas quando a água doce a dilui, as “condições se tornam mais favoráveis”.
À medida que o clima aquece, mais bactérias sobrevivem durante o inverno, o que agrava os surtos no verão porque começamos de um nível já elevado.
Dra. Rachel Noble, professora da Universidade da Carolina do Norte em Chapel Hill que estuda o Vibrio desde o início dos anos 2000, diz à CNN que o aumento da prevalência desta bactéria potencialmente letal está se “repetindo globalmente”, indicando uma “complexidade de questões relacionadas às mudanças climáticas”.
“Este não será o único patógeno que aumentará diante das mudanças climáticas”, afirma Noble. “É apenas um exemplo, mas um do qual podemos realmente aprender”.
A conscientização salva vidas
Lyons está incentivando outros a aprenderem sobre o Vibrio e espera que líderes locais divulguem informações colocando sinalizações adicionais para alertar tanto residentes quanto visitantes. Quaisquer ferimentos, mesmo um pequeno arranhão, devem ser completamente lavados com sabão e água corrente limpa, segundo o CDC.
“Espero que minha história ajude as pessoas a entenderem o que procurar”, diz Lyons. Isso pode até “salvar uma vida”.
Se você desenvolver sintomas, “procure ajuda imediatamente e vá para a emergência”, insiste Lyons. “Essa é a melhor coisa a fazer. Apenas vá e, esperançosamente, você encontrará alguém que reconhecerá o problema pelo que ele é, porque um diagnóstico errado pode ser uma sentença de morte. Realmente pode ser”.
Fonte: www.cnnbrasil.com.br